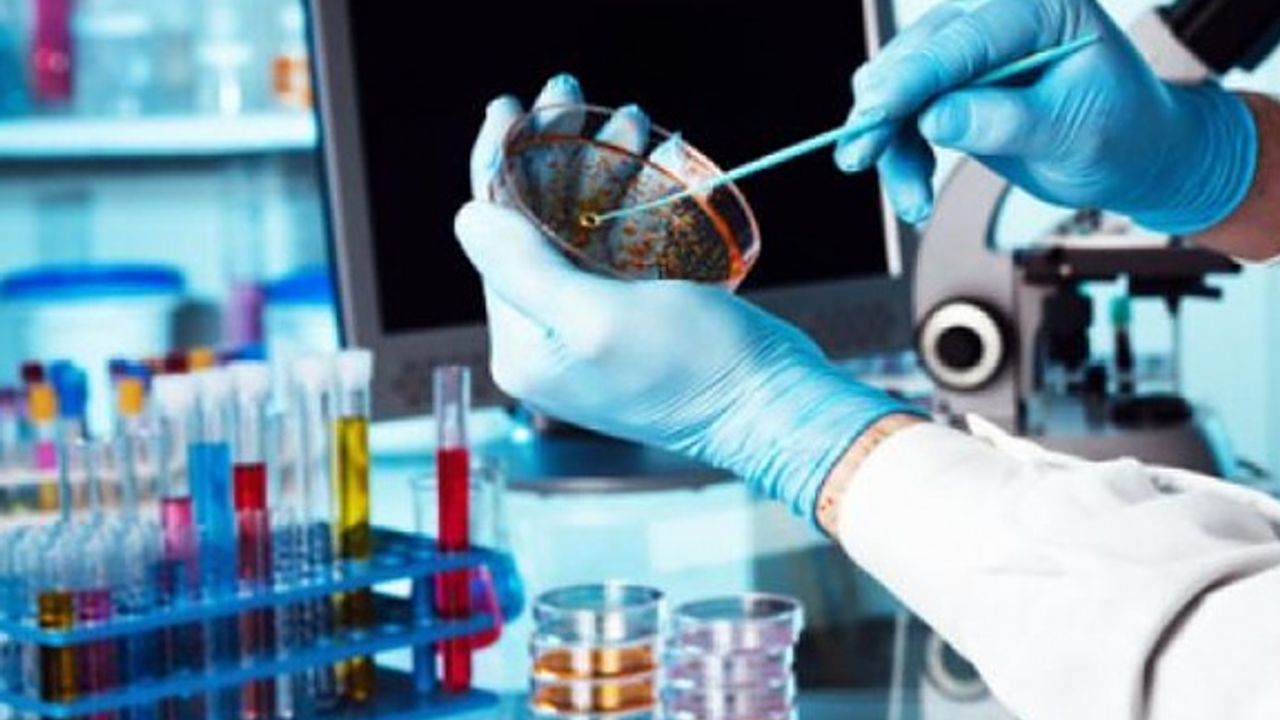

ilan.gov.tr’de yer alan ilana göre Aksaray Üniversitesi Eğitim ve Araştırma Hastanesi, tıbbi sarf malzeme satın alacak.
ilan.gov.tr’de yer alan ilana göre Aksaray Üniversitesi Eğitim ve Araştırma Hastanesi, 3 kalem muayene eldiveni (pudrasız) alımı mal alımını 4734 sayılı Kamu İhale Kanununun 19 uncu maddesine göre açık ihale usulü ile ihale edecek. Teklifler sadece elektronik ortamda EKAP üzerinden alınacak.
Teklif fiyatı ihale komisyonu tarafından aşırı düşük olarak tespit edilen isteklilerden Kanunun 38 inci maddesine göre açıklama istenecek.
Ayrıntılı bilgi için tıklayınız.
İlan No: 1752125
Muhabir: Haber Merkezi